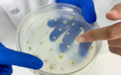
室内豪华套房室外模拟考场 看甘肃肃州好种子养成记
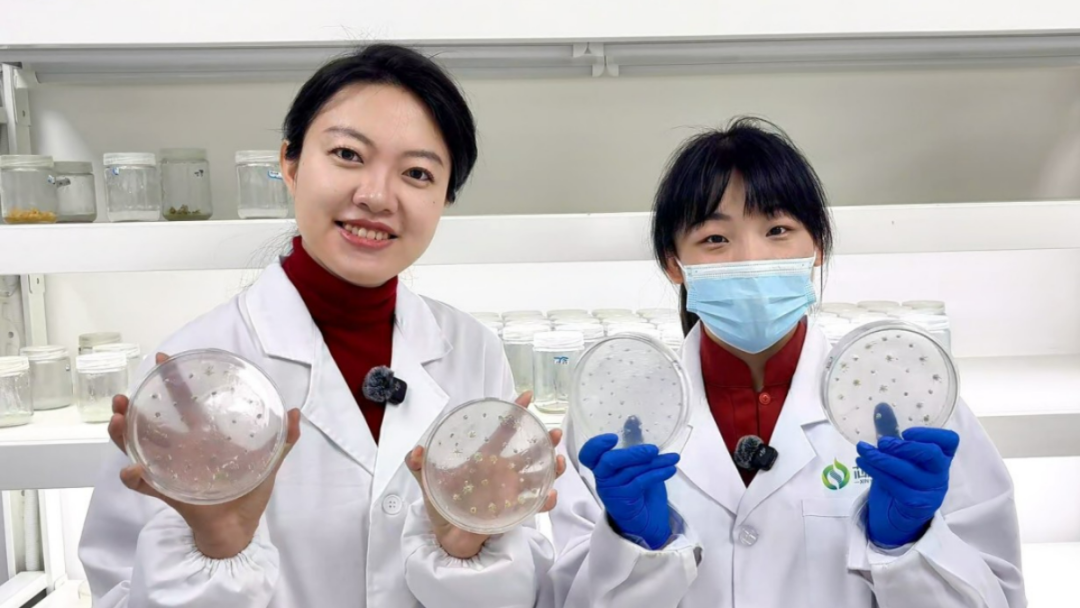
3月25日(32)_副本.jpg

室内豪华套房室外模拟考场 看甘肃肃州好种子养成记


独家抢先看
在肃州
春耕的序曲并非只在田间奏响
从显微镜下的“神奇孢子”
到气候室里的专属“豪华套房”
一粒洋葱种子在春天的实验室里
走完了一场
关于成长与丰收的蜕变之旅……

育种室的“神奇孢子”
提起包子,大家会想起热气腾腾的晨间美味;而在肃州的生物技术育种室里,研究员们正与另一种“孢子”打交道——洋葱大孢子,它是洋葱单倍体育种的起点。从洋葱花序上切下的一朵朵小花,内里便蕴藏着这种拥有无限潜能的“生命原点”。


“单倍体育种的第一步,可以理解为给洋葱‘开分身’。”酒泉芯农研种业科技有限责任公司生物技术育种室负责人杨婉介绍道。
“我们通过培养、诱导洋葱大孢子,先获得关键的中间材料,再由此培育出遗传背景纯合的二倍体植株,从而快速创制全新的纯合品系。”




过去,老一辈农人靠经验筛选良种;如今,科研人员在显微镜下精准挑选“潜力股”,从而培育出抗病、高产、风味更佳的洋葱新品种,这正是科技为农业注入的澎湃动能。

气候室的植株“试炼场”
由大孢子发育而来的胚状体成功再生为小植株,它们便走出培养皿、获得入住“豪华套房”的资格,来到“种子成长记”的下一站——人工气候室。
室内人工气候室就像洋葱植株的“幼儿园”。常年将环境维持在温度20℃、湿度40%-60%的区间,为每一株娇弱幼苗提供专属成长空间,帮助它们平稳度过从实验室到自然环境的“炼苗”适应期。


而在室外人工气候室,又是另一番景象。洋葱植株扎根于广阔土壤,在这里自由舒展枝叶、沐浴阳光、茁壮成长,直至抽出花序,最终结出饱满的种子。
“这个室外气候室,能打破季节与地域的限制。”杨婉介绍道,它可以复现田间遇到的各种环境条件,如同为种子设立了一个全方位的“模拟考场”。
“让洋葱种子在面对病害、干旱、寒冷等挑战时‘优中选优’,从而加速整个育种进程,显著提升育种的效率与可靠性。”

“我们希望通过这些生物技术手段,赋能传统育种工作,培育出更多抗逆性强、品质优良的本土优势品种。”杨婉的目光坚定而充满期待,“让咱们陇原沃土孕育的好种子,走向更广阔的市场与天地。”
当户外依然春寒料峭,肃州已经为一个季节的丰收,准备好了最优秀的“候选者”。科技育种的“魔力”,就是让希望的萌芽不再被动等待天气,而是主动匹配土地的期待。
当实验田里的幼苗最终走向解冻的田野,它们带去的,不仅是高产抗病的基因,更是新农人用智慧写给春天的温情诗篇。
记者丨吴歌 杨明娇
(中共肃州区委宣传部官方公众号)






